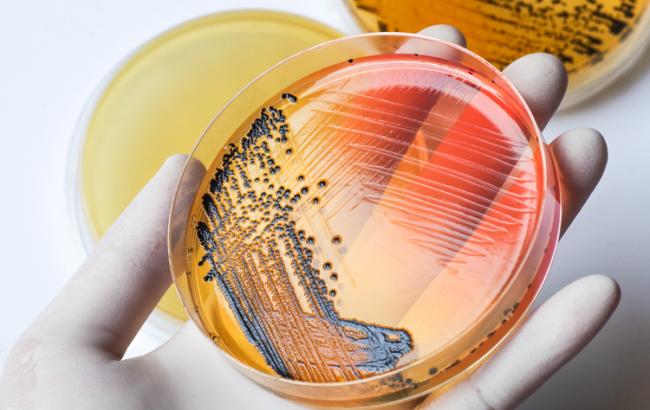

В кафе Николаева люди заболели сальмонеллезом: зафиксировано пять случаев
Фото: Сальмонеллез (Chansom Pantip/Shutterstock.com)
Фото: Сальмонеллез (Chansom Pantip/Shutterstock.com)
12 февраля в Николаеве зафиксировали пять случаев заболевания сальмонеллезом. Отмечается, что все люди посещали кафе "Де Густо", где отведали отравленную пищу. Заведение общественного питания находится на на ул. Строителей, 3б. Об этом сообщает издание "Новости-N".
Первое заболевание сальмонеллезом в городе зафиксировали 4 февраля. В настоящее время этот диагноз врачи подтверждили у пяти пациентов. Все заболевшие госпитализированы в Николаевскую областную инфекционную больницу.
 Фото: Кафе "Де Густо" (google.com.ua maps)
Фото: Кафе "Де Густо" (google.com.ua maps)
В кафе, которое посещали все заболевшие, провели дезинфекцию. Взяты на анализы пробы блюд и воды, проверены сотрудники и их контакты. Результаты анализов пока не известны.
Сальмонеллез – инфекционное заболевание, поражающее в первую очередь органы желудочно-кишечного тракта. Возбудителем сальмонеллеза являются бактерии рода сальмонелла. Для сальмонеллеза характерно тяжелое течение, а риск заражения болезнью достаточно велик, поэтому любой человек должен знать, как проявляется это заболевание, и как его избежать.
Как ранее сообщалось, Lactalis отзывает более 12 млн пачек детского питания из-за сальмонеллы.

